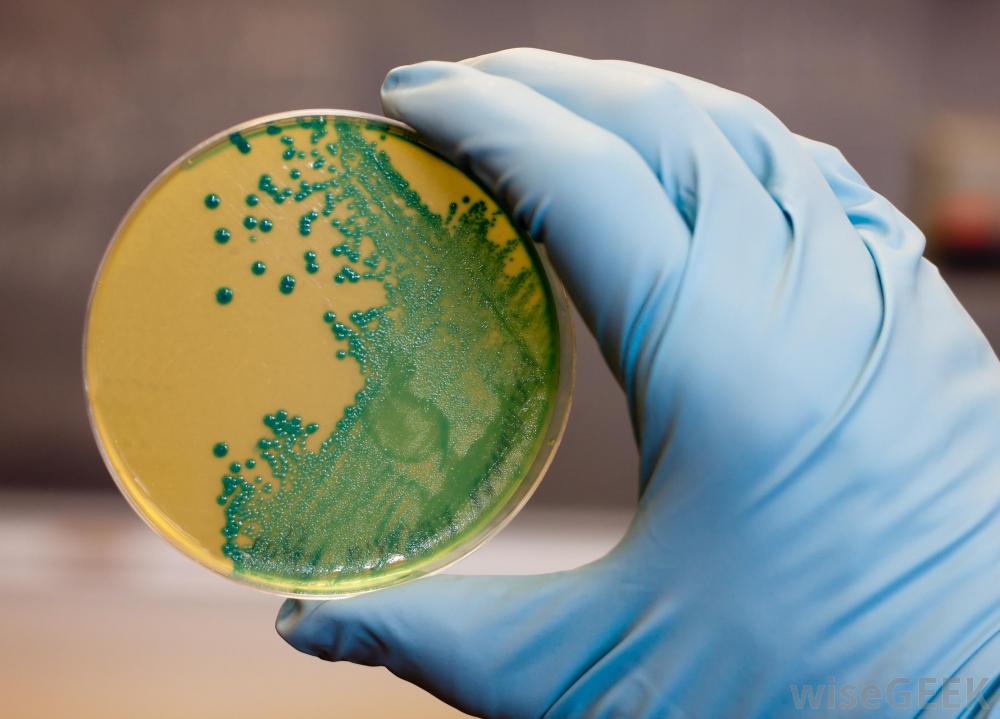

微生物学是研究微生物如细菌、真菌和其他微生物的科学。因为它是一门非常广泛的科学,微生物学职业有几种不同的类型。科学家通常专注于他们研究的生物体类型和他们所从事的行业。微生物学职业在许多不同的环境中都有,比...
微生物学是研究微生物如细菌、真菌和其他微生物的科学。因为它是一门非常广泛的科学,微生物学职业有几种不同的类型。科学家通常专注于他们研究的生物体类型和他们所从事的行业。微生物学职业在许多不同的环境中都有,比如大学,制药公司,生物技术实验室,微生物学家可以用培养皿来研究细菌微生物学家研究特定类型的微生物。例如,细菌学家研究不同类型的细菌,以了解它们的生命周期、结构和功能。他们可以试验不同类型的抗菌溶液,以消除样本中的有害细菌。病毒学家研究病毒的性质和方式产生不同的菌株。真菌学家关注真菌,原动物学家研究藻类和其他原生生物。

微生物学家在公共和私营部门都有工作所有专业领域的微生物学职业都在不同的工作环境中找到。许多微生物学家受雇于大学,在那里他们可以领导实验室的研究团队并教授高级科学课程大学微生物学家培养新一代研究人员,微生物学家将在未来的职业生涯中收集有害微生物样本研究和开发机构提供多种微生物学职业。制药公司雇用的微生物学家通常是团队合作,开发针对各种疾病的情感药物。他们可能会花费数月甚至数年的时间研究特定病毒或一个团队用培养物和组织样本进行实验,以确定新药物对抗疾病的有效性。一旦一种药物显示出前景,微生物学家可能会建议对动物或人类进行临床试验,以确认实验室结果

微生物学家可受雇于制药公司。生物技术行业雇用微生物学家确定微生物如何对社会有益。一些微生物学家在食品科学实验室工作,研究防腐剂、潜在有益的益生菌和食品中发现的有害病原体。医学微生物学家可能在医院或医学实验室工作,研究和诊断各种细菌和病毒性疾病医学微生物学家通常是训练有素的医生,他们积极从事这类微生物疾病的治疗工作,医学微生物学家对微生物免疫学的发展、人体免疫系统的研究以及对人体有益和有害的微生物的研究至关重要

许多人开始在实验室从事微生物学工作,担任研究助理,负责记录实验结果。其他微生物学家可能从事环境研究科学研究,研究土壤、空气、水和活的样本,以确定某些微生物在不同环境下如何茁壮成长。细胞微生物学家在最基本的水平上研究微生物的功能和组成,并将他们的发现应用于农业、食品,医学研究,不管是什么学科或行业,微生物学家对于保持人们的健康和揭开微小世界的奥秘至关重要。
研究和开发机构提供多种微生物学职业。